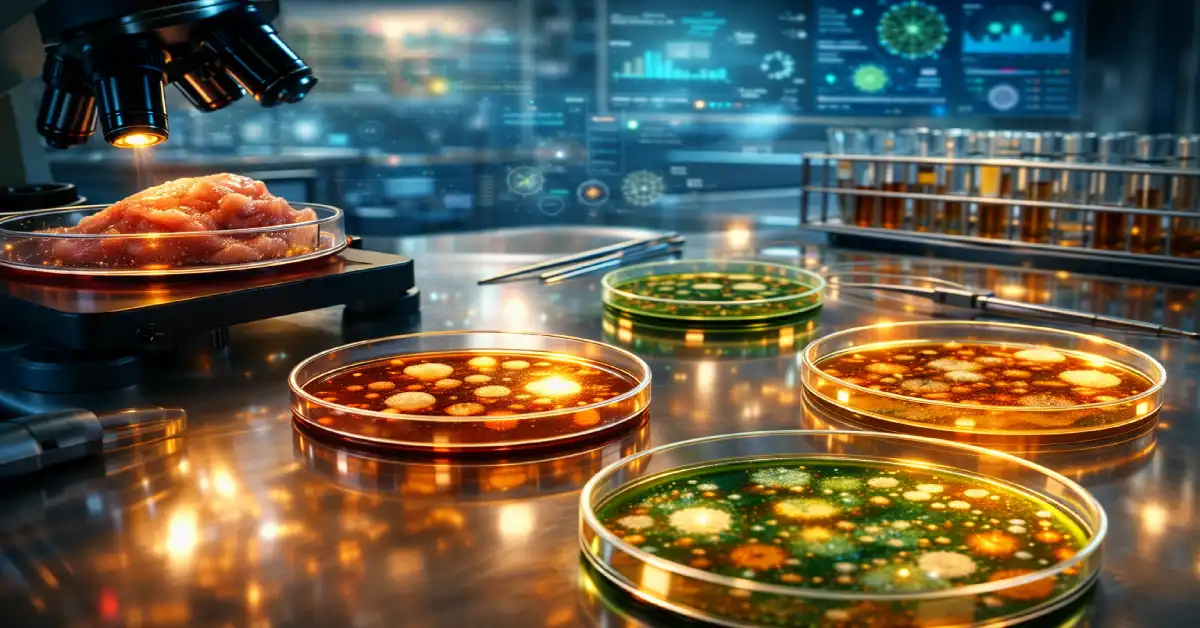
اشتباهات رایج در برداشت از نتایج تست میکروبیولوژی مواد غذایی

تست میکروبیولوژی مواد غذایی | وقتی علم جلوی ریسکهای پنهان را میگیرد

اگر قرار باشد فقط با یک عدد، سرنوشت یک ماده غذایی تعیین شود، چقدر میتوان به آن اعتماد کرد؟
اینجاست که تست میکروبیولوژی مواد غذایی وارد میدان میشود؛ نه بهعنوان یک بررسی ساده آزمایشگاهی، بلکه بهعنوان مرجعی که مرز میان «ایمنی واقعی» و «خطر پنهان» را مشخص میکند.
آنچه در این آزمایشها به دست میآید، صرفاً گزارش میکروبها نیست؛ برای بررسی کاملتر، تستهای کلیدی برای اطمینان از سلامت مواد غذایی را ببینید.
هر نتیجه، ترجمهای علمی از وضعیت واقعی یک محصول است؛ ترجمهای که میتواند مسیر عرضه را باز کند یا زنگ خطر را به صدا درآورد. عددها ممکن است بیطرف به نظر برسند، اما تفسیر آنهاست که تصمیم میسازد؛ تصمیمی که مستقیماً با سلامت مصرفکننده گره خورده است.
حالا سؤال اصلی این است:
آیا فقط خواندن نتیجه کافی است، یا باید بلد باشیم آن را بفهمیم؟
اگر پاسخ دومی است، ادامه این مطلب دقیقاً برای شما نوشته شده است.
تست میکروبیولوژی مواد غذایی دقیقاً چه چیزی را بررسی میکند؟
برخلاف تصور رایج، تست میکروبیولوژی مواد غذایی فقط دیدن میکروبها زیر میکروسکوپ نیست؛ برای آشنایی با محیط انجام این آزمایشها، ببینید آزمایشگاه میکروبیولوژی چیست. این آزمونها طراحی شدهاند تا به یک سؤال کلیدی پاسخ دهند:
آیا این ماده غذایی، در شرایط واقعی مصرف، ایمن هست یا نه؟
برای رسیدن به این پاسخ، چند بررسی بههمپیوسته انجام میشود:
- شناسایی میکروارگانیسمها
تشخیص نوع آلودگی؛ از باکتریها و مخمرها تا قارچها، چون هرکدام رفتار و ریسک متفاوتی دارند.
- شمارش میکروبی
اندازهگیری دقیق میزان آلودگی، نه بر اساس حدس، بلکه با روشهای کمی معتبر.
- تشخیص عوامل بیماریزا
شناسایی میکروبهایی که حتی در مقدار کم هم میتوانند سلامت مصرفکننده را تهدید کنند.
- کنترل ایمنی و بهداشت نمونهها
مقایسه نتایج با حدود مجاز تعیینشده در استانداردهای بینالمللی، متناسب با نوع محصول.
- تفسیر علمی نتایج
تبدیل دادههای آزمایشگاهی به یک قضاوت قابل اتکا؛ جایی که نتیجه صرفاً «خوانده» نمیشود، بلکه فهمیده میشود، نمونههای واقعی در آزمایشگاههای غذایی تهران این موضوع را نشان میدهند.
🔹 به همین دلیل، تست میکروبیولوژی مواد غذایی فقط یک گزارش آزمایشگاهی نیست؛
این تست، ابزاری برای تصمیمگیری آگاهانه درباره سلامت محصول، ادامه تولید یا توقف آن است.

چرا عدد آزمایش بهتنهایی مبنای تصمیم نیست؟
در میکروبیولوژی مواد غذایی، نتیجه آزمایش فقط زمانی معنا دارد که در بستر درست خودش خوانده شود.
عدد، خروجی یک زنجیره است؛ نه خود واقعیت.
💢 نتیجه میتواند گمراهکننده باشد اگر:
- نمونه انتخابشده نماینده واقعی کل محصول یا بچ تولید نباشد
- شرایط نگهداری و انتقال، حتی در بازهای کوتاه، از محدوده استاندارد خارج شده باشد
- روش آزمون با نوع محصول، فرمولاسیون یا مرحله تولید تطابق نداشته باشد
- نتیجه بدون مقایسه با استاندارد مرجع و شرایط تولید تفسیر شود
در چنین شرایطی، گزارش آزمایش «اشتباه» نیست؛ اما تصمیمی که بر اساس آن گرفته میشود میتواند اشتباه باشد.
چه عواملی اعتبار تست میکروبیولوژی مواد غذایی را تعیین میکنند؟
در تست میکروبیولوژی مواد غذایی، اعتبار نتیجه به خود آزمایش محدود نمیشود؛ به زنجیرهای از کنترلها وابسته است که اگر یکی از آنها ضعیف باشد، کل نتیجه زیر سؤال میرود.
✅ نخست، کیفیت نمونهبرداری اهمیت دارد. نتیجه زمانی قابل اتکاست که نمونه، تصویر واقعی از کل محصول باشد، نه یک انتخاب تصادفی یا محدود.
✅ در مرحله بعد، شرایط نگهداری و انتقال نقش تعیینکننده دارند. تغییرات دما، تأخیر زمانی یا آلودگی ثانویه میتوانند نتیجه را بدون آنکه در ظاهر مشخص باشد، تحت تأثیر قرار دهند.
✅ انتخاب روش آزمون نیز باید دقیقاً متناسب با نوع ماده غذایی و هدف بررسی باشد. روشی که برای یک محصول مناسب است، الزاماً برای محصول دیگر پاسخگو نیست.
✅در نهایت، تطابق با استانداردهای مرجع و کنترل کیفیت داخلی آزمایشگاه مشخص میکند که نتیجه تا چه حد قابل استناد است؛ از کالیبراسیون تجهیزات گرفته تا پایش مداوم فرآیندها.
در چنین چارچوبی، عدد حاصل از آزمایش معنا پیدا میکند و میتواند مبنای تصمیم حرفهای قرار بگیرد.
کاربردهای حیاتی تست میکروبیولوژی مواد غذایی
تست میکروبیولوژی مواد غذایی فراتر از یک آزمایش ساده است؛ در صنایع مختلف، این تستها نقش حیاتی در تضمین ایمنی، کیفیت و تصمیمگیری علمی دارند. جدول زیر به شکل شفاف و قابل فهم کاربردهای اصلی این تست را نشان میدهد:
| حوزه کاربرد | نقش تست میکروبیولوژی مواد غذایی | نکته کلیدی |
|---|---|---|
| صنایع غذایی و آشامیدنی | آخرین سد قبل از رسیدن محصول به مصرفکننده | تضمین ایمنی و سلامت غذایی |
| داروسازی | کوچکترین آلودگی میتواند اثر درمانی دارو را تغییر دهد | حفظ اثربخشی و استاندارد دارویی |
| بهداشت و درمان | سلامت انسان مستقیماً وابسته به نتایج آزمایش است | تصمیمات بالینی و بهداشتی صحیح |
| کنترل محیطی | نظارت بر آب، هوا و سطوح برای جلوگیری از رشد میکروبها | پیشگیری از آلودگی محیطی و جلوگیری از شیوع بیماریها |
| تحقیقات علمی | دادههای معتبر و قابل اعتماد از همین نقطه شروع میشوند | پایه مطالعات علمی و توسعه فناوری |
اشتباهات رایج در برداشت از نتایج تست میکروبیولوژی مواد غذایی
بسیاری فکر میکنند وقتی عدد آزمایش را میبینند، همه چیز روشن است. اما واقعیت این است: مشکل اغلب در تفسیر است، نه خود عدد. رایجترین اشتباهها:
- نادیده گرفتن استانداردها: نگاه سطحی به اعداد بدون توجه به معیارهای بینالمللی
- مقایسه نادرست محصولات: تصور اینکه همه محصولات شرایط مشابهی دارند
- تعمیم نتیجه یک نمونه به کل تولید: یک نمونه محدود نمیتواند وضعیت کل محصول را نشان دهد
📌 اینجا نقطهای است که تست میکروبیولوژی مواد غذایی از یک آزمایش ساده به یک ابزار حیاتی برای تصمیمگیری و تضمین ایمنی واقعی محصول تبدیل میشود.
❓ سوالات متداول
1️⃣ تست میکروبیولوژی مواد غذایی دقیقاً چه کاری انجام میدهد؟
این تست حضور، نوع و میزان میکروارگانیسمها را بررسی میکند تا مشخص شود محصول ایمن است یا خطر بالقوه دارد.
2️⃣ آیا نتایج آزمایش همیشه قابل اعتماد هستند؟
نتایج زمانی معتبرند که نمونهبرداری، روش آزمون و تفسیر مطابق استانداردهای بینالمللی باشد؛ در غیر این صورت عدد تنها، گمراهکننده است.
3️⃣ چرا یک نمونه ممکن است مردود شود ولی کل تولید سالم باشد؟
چون نتیجه فقط مربوط به همان نمونه و شرایط خاص است؛ تعمیم آن بدون تحلیل آماری صحیح، اشتباه است.
4️⃣ تفاوت تست میکروبیولوژی با آزمایش شیمیایی چیست؟
در شیمی با ترکیبات ثابت سروکار داریم، اما در میکروبیولوژی موجودات زنده بررسی میشوند؛ بنابراین زمان، شرایط محیطی و تفسیر انسانی اهمیت بسیار بیشتری دارد.
5️⃣ تست میکروبیولوژی مواد غذایی چه نقشی در تضمین سلامت مصرفکننده دارد؟
این تست آخرین سد پیش از عرضه محصول است و مشخص میکند آیا ماده غذایی ایمن است یا باید اصلاح یا حذف شود.
نتیجهگیری؛ وقتی علم حرف میزند، تصمیمها امن میشوند
تست میکروبیولوژی مواد غذایی فراتر از یک بررسی ساده است؛ این یک ابزار واقعی برای محافظت از سلامت انسان است. عددها بدون تفسیر علمی، فقط دادهاند؛ اما وقتی متخصصین مسیر دادهها را تحلیل کنند، تصمیم درست و ایمن روشن میشود.
حالا نوبت شماست:
آیا تا به حال با نتایج آزمایش اشتباه روبهرو شدهاید؟
یا تجربهای داشتهاید که تصمیمگیری بر اساس داده دقیق، جلوی مشکل بزرگی را گرفته باشد؟
👇 دیدگاه و تجربه خود را با ما به اشتراک بگذارید و بخشی از بحث علمی شوید.
منابع:

